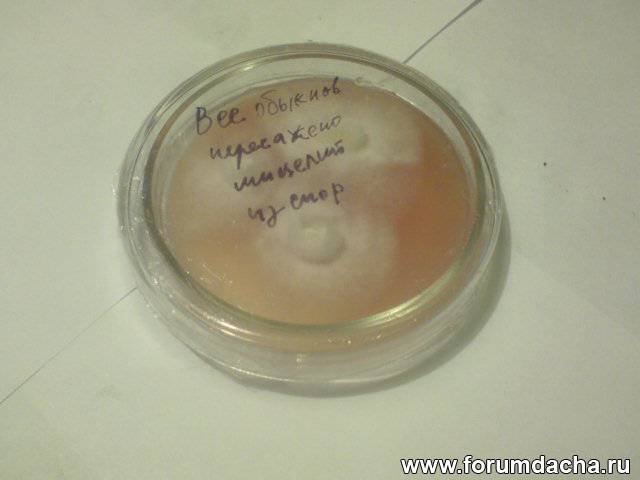

|

| Автор |
Сообщение |
Александр Дворянинов |
|
|
Зарегистрирован: 30.05.2012
Сообщения: 482
|

|
08-10-2012, 12:17 |
 Заголовок сообщения: |
| А.Ю. писал(а): |
| То есть не только мицелий полученный из плодового тела, но и полученный из спор даст плодовые тела. |
После образования дикариотического мицелия, да.
| А.Ю. писал(а): |
| Из чего ее делают? |
На чём произрастает культура.
|
|
А.Ю. |
|
|
Зарегистрирован: 02.05.2011
Сообщения: 182
Откуда: Москва
|

|
08-10-2012, 13:01 |
 Заголовок сообщения: |
| Александр Дворянинов писал(а): |
| А.Ю. писал(а): |
| Из чего ее делают? |
На чём произрастает культура. |
В природных условиях в почве и на деревьях, в лабораториях в искусственно сделанных питательных средах. Таки что вы имели в виду?
|
|
Александр Дворянинов |
|
|
Зарегистрирован: 30.05.2012
Сообщения: 482
|

|
08-10-2012, 13:25 |
 Заголовок сообщения: |
В природных условиях.
|
|
А.Ю. |
|
|
Зарегистрирован: 02.05.2011
Сообщения: 182
Откуда: Москва
|

|
09-10-2012, 08:17 |
 Заголовок сообщения: |
| Александр Дворянинов писал(а): |
| В природных условиях. |
Спасибо
|
|
А.Ю. |
|
|
Зарегистрирован: 02.05.2011
Сообщения: 182
Откуда: Москва
|

|
16-10-2012, 21:45 |
 Заголовок сообщения: |
Александр Дворянинов, при приготовлении агаровой среды с левомицитином, я делаю раствор 50 мг левомицитина на 200 мл жидкости.
С гентомицином также?
|
|
Александр Дворянинов |
|
|
Зарегистрирован: 30.05.2012
Сообщения: 482
|

|
17-10-2012, 07:46 |
 Заголовок сообщения: |
| А.Ю. писал(а): |
Александр Дворянинов, при приготовлении агаровой среды с левомицитином, я делаю раствор 50 мг левомицитина на 200 мл жидкости.
С гентомицином также? |
1 мл. на 300 мл среды, добавляю после стерилизации, хотя он термостабилен.
|
|
А.Ю. |
|
|
Зарегистрирован: 02.05.2011
Сообщения: 182
Откуда: Москва
|

|
17-10-2012, 11:40 |
 Заголовок сообщения: |
ААлександр , спасибо.
Уточнение. С каким содержанием гентомицина в ампулах в данном случае идет речь? Бывает 30 мг/мл и 40 мг/мл
То есть сколько мг гентомицина в одном мл в тех ампулах которые вы разводите в 300 мл среды?
|
|
Александр Дворянинов |
|
|
Зарегистрирован: 30.05.2012
Сообщения: 482
|

|
17-10-2012, 13:37 |
 Заголовок сообщения: |
| А.Ю. писал(а): |
ААлександр , спасибо.
Уточнение. С каким содержанием гентомицина в ампулах в данном случае идет речь? Бывает 30 мг/мл и 40 мг/мл
То есть сколько мг гентомицина в одном мл в тех ампулах которые вы разводите в 300 мл среды? |
Особо роли не играет, так как гентамицин и левомитетин, полностью не ингибируют рост конкурентов, дают лишь некоторый кратковременный эффект, задержки в росте конкурента. Тем самым дают культуре несколько вырваться вперёд, тут уж не зевайте и отделяйте культуру на новую среду.
|
|
А.Ю. |
|
|
Зарегистрирован: 02.05.2011
Сообщения: 182
Откуда: Москва
|

|
17-10-2012, 13:50 |
 Заголовок сообщения: |
Понял, но вы как-то показывали фото на которых антибиотика было больше чем надо и в тех баночках вообще ничего не выросло, ни полезного, ни вредного.. Поэтому я и спросил какой концентрации ампулы у вас.
|
|
Александр Дворянинов |
|
|
Зарегистрирован: 30.05.2012
Сообщения: 482
|

|
17-10-2012, 14:51 |
 Заголовок сообщения: |
| А.Ю. писал(а): |
| Понял, но вы как-то показывали фото на которых антибиотика было больше чем надо и в тех баночках вообще ничего не выросло, ни полезного, ни вредного.. Поэтому я и спросил какой концентрации ампулы у вас. |
Там была запредельная концентрация, когда действительно ничего не выросло. Нам нужно что бы росла культура.
|
|
А.Ю. |
|
|
Зарегистрирован: 02.05.2011
Сообщения: 182
Откуда: Москва
|

|
22-10-2012, 21:24 |
 Заголовок сообщения: |
пересадил мицелий из спор веселки обыкновенной на новую агаровую среду. Среда получилась - объедение. Споры начали расти очень быстро.

|
|
А.Ю. |
|
|
Зарегистрирован: 02.05.2011
Сообщения: 182
Откуда: Москва
|

|
23-10-2012, 11:59 |
 Заголовок сообщения: |
вот такой у меня главбокс, который мне заменяет ламинар. На втулки я раньше натягивал резиновые перчатки, но это не совсем удобно для того, чтобы оперативно что-то из главбокса вынуть или засунуть в него, оскольку крышку в процессе лучше не снимать. Через верх во внутрь однозначно попадет гадостей больше, чем через открытые отверстия сбоку. Поэтому я дезинфицирую стенки и крышку изнутри, а далее работаю в латексных перчатках, которые тоже мою в спирте перед началом работ. Чашка Петри через втулки проходит.
Кстати, можно обходиться и без бактерицидной лампы.

|
|
А.Ю. |
|
|
Зарегистрирован: 02.05.2011
Сообщения: 182
Откуда: Москва
|

|
23-10-2012, 16:12 |
 Заголовок сообщения: |
Александр Дворянинов, вопрос.
Заметил, что мицелий выросший из спор имеет ватную консистенцию.
А мицелий от кусочка плодового тела и даже будучи пересаженным на новую среду имеет вид совсем другой,тоже ватные, но как бы как бы радиально-направленные спиральки.
Вы замечали? Чем это объясняется?
|
|
Romul |
|
|
Зарегистрирован: 19.04.2012
Сообщения: 318
Откуда: Москва
|

|
23-10-2012, 16:57 |
 Заголовок сообщения: |
| А.Ю. писал(а): |
вот такой у меня главбокс, который мне заменяет ламинар. На втулки я раньше натягивал резиновые перчатки, но это не совсем удобно для того, чтобы оперативно что-то из главбокса вынуть или засунуть в него, оскольку крышку в процессе лучше не снимать. Через верх во внутрь однозначно попадет гадостей больше, чем через открытые отверстия сбоку. Поэтому я дезинфицирую стенки и крышку изнутри, а далее работаю в латексных перчатках, которые тоже мою в спирте перед началом работ. Чашка Петри через втулки проходит.
Кстати, можно обходиться и без бактерицидной лампы.
 |
Ничего такой главбокс. Андрей, у меня вопрос: "Когда горелку поджигаете крышка не плавится"?
|
|
А.Ю. |
|
|
Зарегистрирован: 02.05.2011
Сообщения: 182
Откуда: Москва
|

|
23-10-2012, 17:05 |
 Заголовок сообщения: |
Рома, я горелку ставлю рядом на табуретке. Сначала инструмент обжигаю, потом окунаю в спирт и сразу еще мокрым заношу внутрь. Внутри протираю ваткой в спирте. Вроде остается чистым.
Собсно работаю сидя на диване перед двумя табуретами. На одном главбокс, на другом горелка. Конечно опасно, типа спирт и огонь. Но тут уж осторожно надо.
Да, и важно крышку с чашки Петри до конца не снимать, а лишь приоткрыть на расстояние достаточное и необходимое, чтобы была щель. Тогда сверху ничего бы на питательную среду не смогло опуститься из воздуха. Ну или опустилось бы но мало.
|
|
Александр Дворянинов |
|
|
Зарегистрирован: 30.05.2012
Сообщения: 482
|

|
23-10-2012, 20:42 |
 Заголовок сообщения: |
| А.Ю. писал(а): |
Александр Дворянинов, вопрос.
Заметил, что мицелий выросший из спор имеет ватную консистенцию.
А мицелий от кусочка плодового тела и даже будучи пересаженным на новую среду имеет вид совсем другой,тоже ватные, но как бы как бы радиально-направленные спиральки.
Вы замечали? Чем это объясняется? |
В дальнейшем, когда мицелий адаптируется к данной пит. среде, он приобретёт линейный рост, и на вид будут видны раздельные гифы. У меня Весёлка Адрина, 3 неделю сидит на лигно среде, всё пробует, подбирает ферменты, когда будет выработан нужный набор ферментов тогда начнётся линейный рост.
|
|
А.Ю. |
|
|
Зарегистрирован: 02.05.2011
Сообщения: 182
Откуда: Москва
|

|
23-10-2012, 21:28 |
 Заголовок сообщения: |
Александр , а скорость освоения среды является показателем адаптации к этой среде?
Линго среда - что это?
Еще забыл добавить. Я заметил разницу структуры мицелия именно по разделу мицелий из спор, мицелий из кусочка плодового тела. Среда одна и та же, а мицелий разный. Мицелий из кусочка мейтаке такой же как из кусочка веселки. Речь не о нитевидности. С одной стороны войлок плотный и густой, с другой стороны спиральки радиально направленные.
|
|
Александр Дворянинов |
|
|
Зарегистрирован: 30.05.2012
Сообщения: 482
|

|
24-10-2012, 07:48 |
 Заголовок сообщения: |
| А.Ю. писал(а): |
Александр , а скорость освоения среды является показателем адаптации к этой среде?
Линго среда - что это?
Еще забыл добавить. Я заметил разницу структуры мицелия именно по разделу мицелий из спор, мицелий из кусочка плодового тела. Среда одна и та же, а мицелий разный. Мицелий из кусочка мейтаке такой же как из кусочка веселки. Речь не о нитевидности. С одной стороны войлок плотный и густой, с другой стороны спиральки радиально направленные. |
Лигно среда это среда содержащая лигно целлюлозу. Не все культуры имеют большую линейную скорость роста, однако какое либо увеличение скорости, говорит о успешной адаптации. Понаблюдайте за культурой в чашке, более длительное время , если сходства с мицелием из плодового тела не будет,вероятнее всего это конкурент. На начальной стадии развития, весь мицелий белый, с некоторыми различиями в оттенках, а в дальнейшем он может приобретать различные цвета, из за начала плодоношения(спороношения) в случае конкурента.
|
|
А.Ю. |
|
|
Зарегистрирован: 02.05.2011
Сообщения: 182
Откуда: Москва
|

|
24-10-2012, 18:11 |
 Заголовок сообщения: |
Понаблюдаю. Но у меня больше вызывает подозрение мицелий из кусочков. Он какой-то не густой, не похож на тот что на разных фотографиях у других людей выращивающих грибы. А тот который у меня из спор - похож.
Еще раз уточняю, если мицелий дал конкурент, то цвет должен поменяться с чисто белого на какой-либо оттенок, да?
|
|
Александр Дворянинов |
|
|
Зарегистрирован: 30.05.2012
Сообщения: 482
|

|
24-10-2012, 18:41 |
 Заголовок сообщения: |
| А.Ю. писал(а): |
| Еще раз уточняю, если мицелий дал конкурент, то цвет должен поменяться с чисто белого на какой-либо оттенок, да? |
Необязательно.
|
|
|
|
|
|
|
 |
|
Вы не можете начинать темы
Вы не можете отвечать на сообщения
Вы не можете редактировать свои сообщения
Вы не можете удалять свои сообщения
Вы не можете голосовать в опросах
Вы не можете вкладывать файлы
Вы можете скачивать файлы
|
|
|